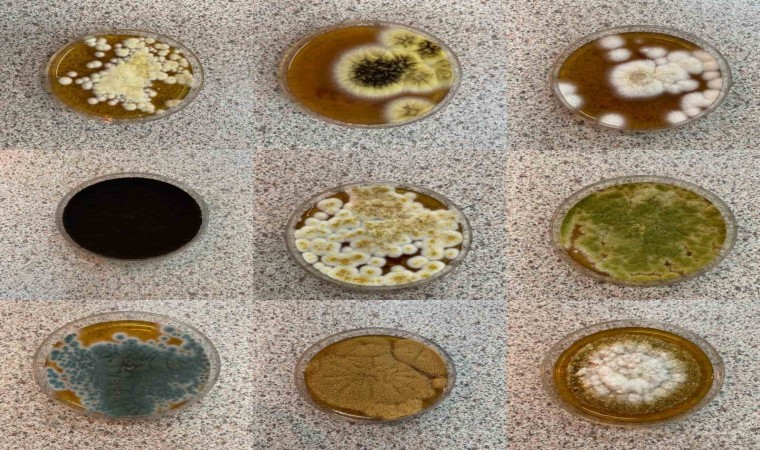

Kastamonu Üniversitesi, Türkiye’nin önemli hayvancılık merkezlerinden biri olan Kastamonu’da, ahırlarda oluşan küf ve mantarların insan ve hayvan sağlığına zararlarını araştırdı. Yapılan incelemelerde 10 ahırda 72 tür ve 18 cins mantar (fungus) tespit edildi. Bunların bir kısmının, hem insan hem de hayvan sağlığını tehdit ettiği belirlendi.
Türkiye’nin önemli hayvancılık merkezlerinden biri olan Kastamonu’da, hem sağlıklı beslenme hem de insan ve hayvanlara bulaşan hastalıklarla ilgili bir çalışma yapıldı. Türkiye’de ilk kez Kastamonu Üniversitesi İhsangazi Meslek Yüksekokulu Veterinerlik Bölümü tarafından yürütülen İhsangazi ilçesinde, "Ahırların İç Ortam Havasında Potansiyel Enfeksiyon Riski Oluşturabilen Fungal Biyoçeşitliliğin Belirlenmesi" adlı projeyle, ahırlardaki küf ve mantarların zararları araştırıldı.
Öğretim Üyesi Dr. Gülay Giray ile Öğretim Görevlisi ve Veteriner Hekim Abdullah Şimşek tarafından yürütülen proje kapsamında, İhsangazi’de bulunan 10 ahır bir yıl boyunca 15 günde bir incelenerek örnekler alındı. Alınan örnekler laboratuvar ortamında analiz edildi. Proje sonunda, 72 tür ve 18 cins fungus (mantar) tespit edildi. Bu mantarların büyük kısmının hem insanlara hem de hayvanlara bulaşabilen ve hastalık oluşturabilen türler olduğu belirlendi.
Dr. Gülay Giray, hava ve suyun canlıların yaşamını sürdürebilmesi için en önemli faktörler olduğunu vurguladı. Havanın, hem yaşam için gerekli maddeleri hem de zararlı mikroorganizmaları içerdiğini belirten Dr. Giray, bu mikroorganizmaların "biyoaerosol" olarak adlandırıldığını söyledi. "Biyoaerosoller, havalandırma sistemleri, kapılar ve pencereler gibi çeşitli yollarla iç ortamlara taşınabilir ve ahırlarda bulunan hayvanlar ve çalışanlar için ciddi enfeksiyon riski oluşturabilir" ifade eden Giray, havadaki mikroorganizmaların çeşitleri ve yoğunluğuna bağlı olarak, hayvanlar ve çalışanlarda çeşitli hastalıkların ortaya çıkabileceğini anlattı.
"Küfler, hayvanlarda hayati tehlike içeren sistemik enfeksiyonlara yol açabilirler"
Ahırlarda temiz hava girişinin sağlanması gerektiğini vurgulayan Dr. Giray, mikrobiyal kontaminantların büyük kısmının bakteriler ve funguslardan oluştuğunu belirtti. Özellikle küf ve mayaların, nemli ortamlarda hızla çoğalabileceğine dikkat çekti. Fungal etmenlerin hem hayvan sağlığı hem de insanların solunum ve bağışıklık sistemleri üzerinde olumsuz etkileri olabileceğini belirten Giray, şunları kaydetti:
"Yaşamaları ve üremeleri için gerekli pH ve su aktivitesi aralığı da oldukça geniştir. Genel yaşam alanlarında oda sıcaklığı olarak kabul edilen 18-25 derece sıcaklık, fungal etmenlerin gelişimi için oldukça uygun sıcaklıklardır. İç ortamda bulunan küfler; solunum ve bağışıklık sistemini etkileyebilir, cilt üzerinde de etkili olabilir. Ayrıca küfler çeşitli organlar üzerinde hayvan sağlığı açısından etki oluşturabilir ve hayvanlarda hayati tehlike içeren sistemik enfeksiyonlara yol açabilirler. Fungal hastalıklar memelilerde 4 farklı şekilde kendini gösterebilir, insanları ve hayvanları enfekte ederler, allerjen olarak rol oynarlar, toksijeniktirler ve inflamasyon (iltihap) reaksiyonlarına neden olurlar. Bir mikotik infeksiyonun başlaması, bulaşan fungal miktara ve konakçının direncine bağlıdır."
Dr. Giray, 80’den fazla mantar cinsinin solunum alerjilerine neden olduğunu ve 100’den fazla mantar türünün insan, hayvan ve bitkilerde enfeksiyonlara yol açtığını aktardı. Alternaria, Cladosporium, Aspergillus, Penicillium ve Fusarium cinslerinin en önemli alerjenler arasında olduğunu da belirten Dr. Giray, ayrıca, Microsporum, Trichophyton ve Sporotrichum türlerinin sığırlarda enfeksiyonlara neden olduğunu vurguladı. Giray, Aspergillus’un solunum sistemine yerleşerek aspergillozis adı verilen ciddi enfeksiyonlara neden olduğunu kaydetti.
"Küfler hayvan sağlığını tehdit ediyor"
Ahırlardaki küf sporlarının, hayvan yemlerinde bozulmaya yol açtığını ve mikotoksinlerin yüksek dozda alındığında hayvanlarda ölüme neden olabileceğini belirten Giray, ortam havasının mikrobiyal kontrolünün önemine de dikkat çekti. 150-1000 kob/m3 küf konsantrasyonunun hayvan sağlığı için tehlikeli olabileceğini söyleyen Dr. Giray, yaptıkları çalışmada 10 ahırda 72 tür ve 18 cins mantar teşhis ettiklerini belirtti. Giray, bu türlerin hayvan ve insan sağlığı açısından tehlikeli olabileceğini vurguladı ve kontrol altına alınmasının hayvan sağlığı için önemli olduğunu söyledi.
Veterinerlik Bölümü Öğretim Görevlisi Abdullah Şimşek, zoonotik hastalıkların hayvanlardan insanlara bulaşma riskine dikkat çekti. Şimşek, özellikle veteriner hekimlerin hayvanlarla yakın temasta bulunmaları sebebiyle birinci derecede risk altında olduklarını belirtti. Veteriner Hekim Şimşek, "Zoonotik hastalıklar, insanlardan hayvanlara veya hayvanlardan insanlara bulaşabilen hastalıklardır. Bu hastalıklara bakteriler, parazitler, mantarlar ve virüsler neden olabilir. 2018 verilerine göre ülkemizde 107 zoonotik hastalığın 13’ü fungal (mantar) türlerinden oluşmaktadır" şeklinde konuştu.
Ringworm adıyla bilinen dermatofit enfeksiyonlarının hayvanlardan insanlara bulaşabildiğini ifade eden Şimşek, bu hastalığın özellikle baş, kulak, kuyruk ve eklem bölgelerinde kızarıklık, kaşıntı ve tüy dökülmesiyle kendini gösterdiğini aktardı. Şimşek, "Mantar enfeksiyonları hayvanlar arasında kolayca yayılabilir ve bu enfeksiyonların bazı türleri insanlara bulaşabilir. Genç hayvanlar, yaşlılara oranla bu hastalığa daha duyarlıdır" diye konuştu.
Mantar enfeksiyonlarının tedavisinde aşının önemli bir yer tuttuğunu vurgulayan Şimşek, "Mantar aşıları ile son yıllarda oldukça iyi sonuçlar alıyoruz. Ancak aşının yanı sıra güneş ışığı, temiz hava ve ahırın nem oranının düşürülmesi de tedavide başarıyı artırır" dedi.
Mantar enfeksiyonlarının özellikle nemli ve kalabalık ahırlarda hızla yayıldığını belirten Şimşek, "Karanlık, nemli ve kapasitesinin üzerinde hayvan bulunduran ahırlarda hastalık yayılma riski çok yüksektir. Sığırlarda görülen aspergillozis ise bronkopnömoni, mastitis ve abortusa neden olabilir. Bu tür hastalıkların önlenmesi için ahır şartlarının iyileştirilmesi önemlidir" diye uyardı.
Şimşek, mantar enfeksiyonlarının sistemik tedavi gerektirdiğini, ancak ileri vakalarda lokal tedavinin zor olduğunu belirterek, veterinerlerin hasta hayvanlara ilişkin kapsamlı bilgiye sahip olmasının teşhis ve tedavide önemli olduğunu vurguladı.

Yorum Yazın
E-posta hesabınız sitede yayımlanmayacaktır. Gerekli alanlar * ile işaretlenmişdir.